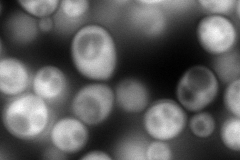

View description
Small heat shock protein (sHSP) with chaperone activity; forms hollow, sphere-shaped oligomers that suppress unfolded proteins aggregation; oligomer activation requires a heat-induced conformational change; not expressed in unstressed cells
Localization:
Intensity:
Fold change:
Significance:
-
C’ GFP library in SD

punctate529.13 -
N' NOP1pr-GFP in SD
cytosol364.975 -
N' TEF2pr-mCherry in SD

cell periphery,vacuole571.81 -
N' NATIVEpr-GFP in SD

cytosol369.302 -
N' TEF2pr-VC and Cyto-VN in SD

#N/A0 -
C’ GFP library in SD+DTT

punctate791.061.49No -
C’ GFP library in SD+H2O2

cytosolN/AN/ANo -
C’ GFP library in Starvation Media

punctateN/AN/AYes -
C’ GFP library on the background of Pup2-DaMP

punctate -
C’ GFP library on the background of CCT mutant

punctate868.2421.64087Yes
